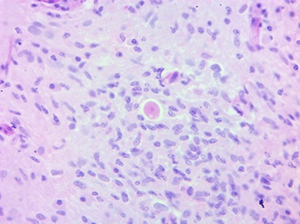

Encefalitis por ameba de vida libre: reporte de caso
Enrique Villarreal García, Edgar Fragoza Sánchez, Arturo Alejandro Carrillo Uzeta, Leonel, Ramírez Abrego, José Raymundo Medina Romero, Eduardo Díaz Juárez
RESUMEN
La encefalitis amebiana granulomatosa es una enfermedad considerada atípica debido a la baja incidencia desde que fue descubierta. Sin embargo, conforme han avanzando los métodos diagnósticos, en retrospectiva, se ha descrito la presencia de esta enfermedad desde principios del siglo XX, identificando a Acanthamoeba spp y Balamuthia mandrillaris como agentes más comunes.
Es una enfermedad de difícil diagnóstico debido al amplio abanico clínico que puede presentar, siendo el sitio anatómico dentro del sistema nervioso central quien determinará estas características. El conocimiento y sospecha de la misma permitirá un abordaje terapéutico oportuno aunque, en la mayoría de los casos, con un desenlace fatal para el paciente.
A continuación se presenta el caso clínico de un paciente masculino de 26 años de edad originario de la ciudad de Durango, México, sin antecedentes de importancia, de ocupación ladrillero, quien sufre golpe con ladrillo en región naso-orbitaria, ingresando al hospital al tercer día del evento con diagnóstico de celulitis periorbitaria izquierda y nasal, cefalea de leve intensidad, rinorrea abundante, hemiparesia fasciocorporal izquierda, parestesia de extremidad superior izquierda, diplopía y vértigo postural. Los estudios imagenológicos revelaron lesiones heterogéneas en el lóbulo occipital, hemisferio cerebeloso izquierdo y tallo cerebral. Se realizó escisión de lesión tumoral cerebelar, con estudio anatomopatológico, reportando encefalitis granulomatosa por presencia de ameba de vida libre. El paciente evolucionó hacia deterioro rostro-caudal declarándose su fallecimiento a los 16 días de su estancia intrahospitalaria.
En el Estado de Durango, México, no se cuenta con casos reportados por infección de ameba de vida libre.
Palabras clave. Encefalitis granulomatosa amebiana, ameba de vida libre, Acanthamoeba spp, Balamuthia mandrillaris
SUMMARY
Granulomatous amoebic encephalitis is a disease considered atypical due to the low incidence since it was discovered. However, as diagnostic methods have progressed, in retrospect, the presence of this disease has been described since the beginning of the 20th century, identifying Acanthamoeba spp. and Balamuthia mandrillaris as the most common agents.
A disease that is difficult to diagnose due to the wide clinical range that it can present, being the anatomical site within the central nervous system that will determine these characteristics. The knowledge and suspicion of it will allow a timely therapeutic approach although, in most cases, with a fatal outcome for the patient.
The clinical case is presented below of a 26 year old male patient from the city of Durang, México, with no significant history, of brick occupation, who suffers a blow with a brick in the naso-orbital region, follows, entering our hospital on the third day of the event with a diagnosis of left periorbital and nasal cellulitis, mild headache, profuse rhinorrhea, left fasciocorporeal hemiparesis, left upper limb parestesia, diplopia, and postural vertigo.
Imaging studies were performed observing heterogeneous lesions in the occipital lobe, left cerebellar hemisphere and brain stem; excision of the cerebellar tumor lesion being carried out, with pathological study, reporting granulomatous encephalitis due to the presence of free-living amoeba. The patient progresses to face-caudal deterioration, declaring his death after 16 days of hospital stay.
Within the state of Durango, Mexico, there are no reported cases of free-living amoeba infection.
Keywords. Amoebic granulomatous encephalitis, free-living amoeba, Acanthamoeba spp, Balamuthia mandrillaris
INTRODUCCIÓN
Se han identificado casos de infecciones por amebas de vida libre (AVL) desde 1909, describiendo su potencial patogénico en 1958, hace 60 años, por Culbertson al inocularlo en ratones y simios. El primer caso humano de meningoencefalitis amebiana fue reportado en Australia en 1965, hace 55 años, primero pensando en Acanthamoeba spp. como agente etiológico y posteriormente identificado como Naegleria Fowleri.1,2 En 1972, 7 años después, se identifica Acanthamoeba spp. como agente etiológico en infecciones humanas, específicamente en encefalitis; inicialmente descrito en pacientes inmunocomprometidos y crónicamente enfermos. En la actualidad, se refiere también en pacientes inmunocompetentes y relacionado por primera vez como causante de queratitis en Reino Unido en 1974 al iniciar la fiebre de los lentes de contacto y notar un aumento de afecciones oculares en estos usuarios.1,2
Finalmente, el primer caso de Balamuthia Mandrillaris fue documentadopor Visversvara, inicialmente descrito en un babuino en 1990 y aislado en humano en 1993.1
Hasta el año 2018 se habían reportado alrededor de 600 casos de encefalitis granulomatosa amebiana (EGA) y meningoencefalitis amebiana primaria (MAP) por ameba de vida libre (AVL), determinando como el principal agente etiológico para MAP a Naegleria fowleri y para EGA Acanthamoeba y Balamuthia.4 No obstante, para el caso de EGA, los reportes señalan que hasta el año 2019 se habían identificado en todo el mundo, 200 casos de EGA por B. madrillaris y poco más de 200 casos por Acanthamoeba spp..4
Los análisis histopatológicos revelan la vía de entrada de estas amebas al sistema nervioso central involucrando metástasis hematógena, a través de heridas en la piel y órganos respiratorios a través de la cavidad nasal sugiriendo seguir el trayecto del nervio olfatorio al cerebro.3,4
Se cree que muchos de los casos de EGA se pierden debido a su alta mortalidad (90-94%) y baja sospecha diagnóstica, cursando estos pacientes un cuadro clínico subagudo o crónico. 5,6,7
Los hallazgos relacionados en el líquido cefalorraquídeo (LCR) incluyen conteo elevado de células blancas, proteínas elevadas, y niveles normales o disminuidos de glucosa, siendo una infección difícil de distinguir de otras enfermedades por este medio.4
En los estudios de imagen se observan lesiones necróticas y hemorrágicas con efecto de masa, empleando tomografía (TAC) y resonancia magnética (RM), sin embargo también resulta difícil diferenciar la lesión de otras causas.8
A pesar de que el diagnóstico definitivo requiere la toma de biopsia para estudio histopatológico, la detección del trofozoito o quiste, es complicado de diferenciar morfológicamente entre Acanthamoeba spp. y B. mandrillaris bajo microscopía de luz.3, 4
El trofozoito de B.mandrillaris observado en cultivos in vitro abarca de 15 a 60 µm de tamaño y presenta brazos que abarcan de filopodios a lamelipodios. Pueden tener más de dos nucléolos en el núcleo; trofozoitos menores de 30 a 40 µm y pequeña filopodia son difíciles de distinguir de histiocitos observados en el LCR.4,9
El trofozoito de Acanthamoeba spp. abarca de 15 a 30 µm, adquiere una forma plana no uniforme y presenta un pseudopodio de movimiento lento. Debido a que su trofozoito se caracteriza por ser corto, puntiagudo y con forma de gancho, además de contar con un nucléolo en su núcleo, es relativamente más fácil distinguir como trofozoito vivo.4,7 Su fase quística surge por exposición a ambientes ásperos, obteniendo la capacidad de supervivencia de hasta 20 años a temperaturas de 0-2 °C y resistencia a antibióticos, cloración y biocidas. 4,7
Debido a claras variantes antigénicas entre ambas amebas, pueden ser diferenciadas por inmunofluorescencia, utilizando anticuerpos específicos, usualmente necesarios para el diagnóstico definitivo.4
En los supervivientes de infecciones de B. mandrillaris se han utilizado múltiples esquemas que incluyen sulfodiazinas, claritromicina, fluconazol, pentamidina, azitromicina, miltefosina, entre otros, siendo esto prueba que no existe un esquema terapéutico farmacológico establecido para infecciones de AVL, prevaleciendo la alta mortalidad en estos pacientes.1,3,4,8. Asimismo, también entre los supervivientes se han descrito casos en los cuales se vincula el uso de cirugía, probablemente contribuyendo a la disminución de la carga parasitaria. 1,3
CASO CLÍNICO
Se presentó un paciente masculino originario de Durango, México, de 26 años de edad, sin antecedentes de importancia, de ocupación ladrillero, quien sufrió un golpe con ladrillo en región naso-orbitaria, ingresado al hospital al tercer día del evento con diagnóstico de celulitis periorbitaria izquierda y nasal. Al interrogatorio dirigido negó antecedente de baño en aguas termales o viajes al extranjero.
En la anamnesis refirió cefalea leve y en la exploración clínica inicial presentó secreción fétida abundante en cavidad orbitaria izquierda, edema palpebral izquierdo, edema nasal, rinorrea purulenta abundante, odinofagia, disartria, diplopía y vértigo postural. Desviación de la comisura labial a la derecha, parestesia en extremidad superior izquierda, y hemiparesia corporal izquierda que imposibilitaba la bipedestación y marcha. Se inició uso de esteroide y antibioticoterapia empírica con remisión de la cefalea, la diplopía y del vértigo postural.
Al tercer día de estancia intrahospitalaria, en la exploración neurológica, se observó:
h.1) Resonancia magnética cerebral con corte sagital y secuencia T1 con gadolinio. Se encontró imagen heterogénea, con efecto de masa y zonas de reforzamiento en el interior. (Figura 1).
h. 2) Resonancia magnética cerebral de corte axial en secuencia T1 con gadolinio. Se identificó a nivel del puente y pedúnculos cerebolosos una imagen con efecto de masa y reforzamiento en el interior; en el hemisferio izquierdo se observó una imagen heterogénea, con zonas de reforzamiento al medio de contraste en el interior. (Figura 2).
h. 3) Resonancia magnética cerebral corte coronal en secuencia T2. Se encontró zona focal heterogénea de predominio hiperintensa sin efecto de masa en lóbulo parietal izquierdo. En el hemisferio cerebeloso se observó imagen de forma lineal hiperintensa con edema perilesional. (Figura 3).
Figura 1. Resonancia magnética cerebral encorte sagital y secuencia T1 con gadolinio.

Figura 2. Resonancia magnética cerebral corte axial en secuencia T1 con gadolinio.

Figura 3. Resonancia magnética cerebral corte coronal en secuencia T2.
i.1) Clínico. Celulitis periorbitaria y meningitis.
i.2) Imagenológico. Absceso cerebral vs neoplasia intra-axial.
i.3) Se realizó punción lumbar: leucocitosis 20,111 células/mm3, LCR proteínas 108 mg/dl, glucosa 18 mg/dl, células 160/ mm3, y polimorfonucleares 70%.
1. Evolución clínica. A 4 días del inicio
Drenaje tipo Caldwell-Luc.
2. Evolución clínica. A 5 días del inicio
Exéresis de lesión cerebral a través de craneotomía suboccipital.
3. Evolución clínica. Del día 6 al día 13 del inicio
Deterioro rostrocaudal progresivo que requirió apoyo ventilatorio y sedación. Se inició tratamiento con anfotericina B al obtener reporte histopatológico definitivo.
Reporte histopatológico
Figura 4. Tinción de Hematoxilina y Eosina.

Figura 5: Tinción Tricómico de Gomori
DISCUSIÓN
Balamuthia Mandrillaris y Acanthamoeba spp. son amebas de vida libre encontrándose de manera ubicua, causantes de encefalitis granulomatosa amebiana (EGA),1,4 enfermedad considerada como atípica por el bajo número de casos detectados. Sin embargo, conforme incremente el conocimiento de la enfermedad la sospecha diagnóstica dirigirá a un aumento progresivo de casos detectados, mayor experiencia y consecuente definición de tratamiento antibiótico específico.
El variado abanico clínico que presenta la enfermedad en el sistema nervioso central depende del sitio anatómico afectado,3 por lo que una adecuada historia clínica y una búsqueda intencionada de síntomas determinará el sitio afectado, el cual se confirmará mediante estudios de imagen.
Poco a poco se ha estandarizado la señalización en los registros epidemiológicos de cada país; de esta forma se ha hecho conciencia de la existencia de esta enfermedad, haciendo cada vez más común agregar como diagnóstico diferencial ante un caso de encefalitis.
No es de extrañar que más del 70% de las encefalitis cursen sin diagnóstico etiológico, aunado a la baja cultura de autopsia y las limitaciones tecnológicas.4,10,11
Alrededor de 600 casos entre encefalitis granulomatosa amebiana (EGA) y meningoencefalitis amebiana primaria (MAP) han sido reportados en todo el mundo y menos del 5% han sido exitosamente curados.4
Se reporta el caso de encefalitis amebiana de vida libre quien presenta una lesión traumática sobre la vía olfatoria,1 con un período subagudo de la enfermedad el cual deriva en su fallecimiento a pesar de las medidas farmacológicas.
El diagnóstico histopatológico definitivo de EGA fue indefinido, atribuido a Acanthamoeba spp. o B. mandrillaris, la dificultad bajo microscopía de luz crea la necesidad de realizar PCR o inmunofluorescencia.
Sin duda, el diagnóstico de encefalitis es común y perfectamente identificable, lo interesante del caso que se presenta es el origen etiológico. Es verdad que en la actualidad la incidencia reportada de afecciones por ameba de vida libre del sistema nervioso central es rara, sin embargo también es una realidad que no está presente como una opción diagnóstica en el Médico tratante, escenario que puede traducirse como un subregistro.
Al respecto, es necesario señalar que el diagnóstico etiológico lo establece el estudio histopatológico. No existe duda que se trata de una ameba de vida libre en sistema nervioso, sin embargo se debe reconocer que no se identificó el género, escenario que puede ser considerado como una limitante en el contexto de conocimiento puro, pero para fines de epidemiológicos, de sospecha diagnóstica y conocimiento del curso habitual de la enfermedad, el escenario no se modifica.
El devenir de la práctica médica deberá retomar la relación entre anamnesis, cuadro clínico, pruebas bioquímicas y de imagen, y aunado a ello tener presente el diagnóstico de una afección por ameba de vida libre como una posibilidad diagnóstica ante un caso de encefalitis.
No se puede negar que el tratamiento en la actualidad ofrece pobres expectativas de sobrevida al paciente, pero es un compromiso de la Medicina que deberá resolver en el corto y mediano plazo.
CONCLUSIÓN
La encefalitis por ameba de vida libre puede tener una incidencia más alta de lo reportado, la ausencia de sospecha diagnóstica lleva a un subregistro de la enfermedad que impide la estandarización de un tratamiento farmacológico efectivo que aumente la sobrevida del paciente; en la medida en que la ameba de vida libre se asuma como agente etiológico probable será parte de la práctica médica habitual.
COMENTARIO
Los autores nos presentan un reporte de caso de Encefalitis por Ameba de vida libre, complementado con una revisión no sistemática de la bibliografía.
Debido a la baja prevalencia de esta afección, su amplio abanico de presentación clínico-neurológica y su alta mortalidad se torna necesario incorporar a este grupo de infecciones dentro de los diagnósticos diferenciales en los casos de encefalitis y lesiones intra-craneanas para aumentar su grado de detección y mejorar las posibilidades evolutivas de los pacientes.
La mayor fortaleza de esta comunicación es dar visibilidad a una entidad nosológica frecuentemente no considerada.
Agradecemos a los autores por la elaboración y entrega de este reporte.
Claudio Centurión.
Sanatorio Aconcagua.
Clínica Vélez Sársfield.
Córdoba.
COMENTARIO
Si bien la Encefalitis por Ameba de Vida Libre es una patología de baja incidencia, considero que la importancia de la misma radica en la alta mortalidad, la cual es consecuencia de no tener un tratamiento preciso, debido a que se trata de una patología de baja incidencia. Este círculo vicioso es el que este tipo de artículos debe romper y felicito a los autores por ello. No obstante, en el caso expuesto, si bien el paciente presentaba una infección franca postraumática, también evidenciaba un cuadro neurológico florido, y se comenzó con tratamiento antibiótico empírico sin tener un estudio de imágenes previo. Esto dificulta la tipificación de los gérmenes involucrados cuando se realiza la biopsia y disminuye sustancialmente las posibilidades de tener un correcto tratamiento.
Javier E. Salazar
Fundación Favaloro